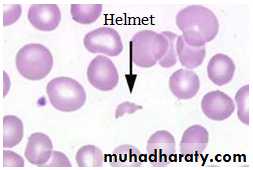
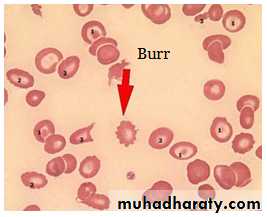

Hemolytic Uremic Syndrome
ByDr. Athal Humo
2015-2016
Hemolytic Uremic Syndrome
HUS is characterized by the triad of microangiopathic hemolytic anemia, thrombocytopenia, and renal injury and is an important cause of acute renal injury in children.HUS typically occurs in children <5 years of age but can occur in older children.
Types of HUS:Typical HUS (D+HUS):
It is the most common type of HUS. It occurs in children <5 years of age.
It is associated with a prodromal diarrheal illness “D+HUS”, contamination of meat, fruit, vegetables, or water with verotoxin (VT) producing E. coli ( most commonly E.coli O157:H7) is responsible for many outbreaks.• Atypical HUS
HUS presenting without a prodrome of diarrhea (D-HUS), may occur at any age.
The clinical course is usually more severe than that of D+HUS.
D-HUS due to:
2ry to infection (Streptococcus pneumoniae, HIV)
Genetic & acquired defects in complement regulation.
Medications.
Malignancy.
SLE.
Pregnancy.
CLINICAL MANIFESTATIONS
Classic D+HUS typically begins as gastroenteritis, often bloody, followed in 7 to 10 days by weakness, lethargy, irritability, and oliguria/anuria.Physical examination reveals irritability, pallor, edema, petechiae, and occasionally hepatosplenomegaly. Dehydration is often present; however, some children have volume overload. Hypertension may be due to volume overload or renal injury.
CNS involvement, including seizure occur in up to 25% of the cases.
Other organs involvement includes: pancreatitis, cardiac dysfunction & colonic perforation.DIAGNOSTIC STUDIES
Common lab finding in HUSEVIDENCE OF MICROANGIOPATHIC HEMOLYTIC ANAEMIA
Anemia
Thrombocytopenia
Presence of schistocytes, helmet cells, & burr cells on peripheral blood
Increase LDH
Decreased haptoglobin
Increased indirect bilirubin
Increased AST
Elevated reticulocyte count
EVIDENCE OF RENAL INJURY
Elevated creatinine
Presence of hematuria, proteinuria, pyuria, cast on urinalysis
OTHER POTENTIAL FINDINGS
Leukocytosis
Postive stool culture for E-coli O157:H7
Postive stool test for shiga toxin
Elevated amylase/ lipase
TREATMENT
Therapy for HUS is supportive and includes volume repletion, control of hypertension, and managing complications of renal insufficiency, including dialysis when indicated.Early hydration during the diarrheal phase may lessen the severity of renal insufficiency.
Red blood cell transfusions are provided as needed.
platelet transfusions are indicated only during active hemorrhage or anticipation of a procedure.
Antibiotics & antidiarrheal agents may increase the risk of developing HUS.
PROGNOSIS
Most children (>95%) with D+HUS survive the acute phase & recover normal renal function.D-HUS, familial cases, and sporadic HUS have poorer outcomes.
Henoch-Schönlein Purpura
ETIOLOGY
Henoch-Schönlein purpura (HSP) is a vasculitis of unknown etiology characterized by inflammation of small blood vessels with leukocytic infiltration of tissue, hemorrhage, and ischemia. The immune complexes associated with HSP are predominantly composed of IgA.EPIDEMIOLOGY
HSP is the most common systemic vasculitis of childhood and cause of nonthrombocytopenic purpura.It occurs primarily in children 3 to 15 years of age, although it has been described in adults.
HSP is slightly more common in boys than girls
Occurs more frequently in the winter than the summer months
CLINICAL MANIFESTATIONS
HSP is characterized by rash, arthritis, and, less frequently, gastrointestinal or renal vasculitis.Rash
The hallmark of HSP is palpable purpura, caused by small vessel inflammation in the skin leading to extravasation of blood into the surrounding tissues. IgA often is deposited in the lesions. Although the rash can occur anywhere on the body, it is classically found in dependent areas, below the waist on the buttocks and lower extremities.
The rash can begin as small macules or urticarial lesions but rapidly progresses to purpura with areas of ecchymosis. The rash also can be accompanied by edema, particularly of the calves and dorsum of the feet, scalp, and scrotum or labia.
Arthritis
Arthritis occurs in 80% of patients with HSP; it can occur in any joint but tends to affect the lower extremities, most commonly the ankles and knees. The arthritis is acute and can be very painful with refusal to bear weight.The arthritis of HSP does not leave any permanent joint damage; it does not typically recur.
GIT
Gastrointestinal involvement occurs in about one half of affected children.
Typically presents as mild to moderate crampy abdominal pain, thought to be due to small vessel involvement of the gastrointestinal tract leading to ischemia.
Less commonly, significant abdominal distention, bloody diarrhea, intussusception, or abdominal perforation occurs and requires emergent intervention.
Gastrointestinal involvement is typically seen during the acute phase of the illness. It may precede the onset of rash.
Renal
One third of children with HSP develop renal involvement, which can be acute or chronic.
Although renal involvement is mild in most cases, acute glomerulonephritis manifested by hematuria, hypertension, or acute renal failure can occur.
Most cases of glomerulonephritis occur within the first few months of presentation, but rarely patients develop late renal disease, which ultimately can lead to chronic renal disease, including renal failure.
CNS
Neurologic manifestations of HSP, caused by hypertension or CNS vasculitis, may also occur. They include intracerebral hemorrhage, seizures, headaches, and behavior changes.
Others
Other less-common potential manifestations of HSP are:Orchitis.
Testicular torsion.
Pancreatitis
Carditis.
Pulmonary hemorrhage.
Inflammatory eye disease.
LABORATORY AND IMAGING STUDIES
No laboratory finding is diagnostic of HSP.Common but nonspecific findings include ESR, CRP, and WBC count are elevated in patients with HSP.
The platelet count is the most important test, because HSP is characterized by nonthrombocytopenic purpura with a normal, or even high, platelet count, differentiating HSP from other causes of purpura that are associated with thrombocytopenia such as autoimmune thrombocytopenia, SLE, or leukemia.
A serum blood urea nitrogen and creatinine should be obtained to evaluate renal function.
Serum albumin levels may be low due to renal or intestinal protein loss.A urinalysis screens for evidence of hematuria. Testing the stool for blood may identify evidence of gut ischemia. Any question of gut perforation requires radiologic investigation
Ultrasound is often used in the setting of gastrointestinal complaints to look for bowel wall edema or the rare occurrence of an associated intussusception.
Barium enema can also be used to both diagnose and treat intussusception.
• Although often unnecessary in typical HSP, biopsies of skin and kidney can provide important diagnostic information, particularly in atypical or severe cases, and characteristically show IgA deposition in affected tissues.
Criteria for Diagnosis of Henoch-Schönlein Purpura
DefinitionCriteria
Raised, palpable hemorrhagic skin lesions in the absence of thrombocytopenia
Palpable purpura
Diffuse abdominal pain or the diagnosis of bowel ischemia; IgA deposits in vessel wall
Bowel angina
Histologic changes showing granulocytes in the walls of arterioles or venulesDiagnostic biopsy
Age ≤20 years at onset of symptomsPediatric age group
The diagnosis of Henoch-Schönlein purpura is based on the presence of two of four criteria.
Skin biopsy of patient with HSP, showing direct immunofluorescence of immunoglobulin A within the walls of dermal capillaries.
TREATMENT
Therapy for HSP is supportive, an emphasis on assuring adequate hydration, nutrition, and analgesia.A short-term course of NSAI drugs can be administered for the acute arthritis.
Systemic corticosteroids usually are reserved for children with GIT disease and provide significant relief of abdominal pain. A typical dosing regimen is prednisone, 1 mg/kg/day for 1 to 2 weeks, followed by a taper schedule. Recurrence of abdominal pain as corticosteroids are weaned may necessitate a longer course of treatment.Acute nephritis typically is treated with corticosteroids but may require more aggressive immunosuppressive therapy.
Although few data are available to demonstrate efficacy, IVIG and plasma exchange are sometimes used in the setting of severe disease.
PROGNOSIS
The prognosis of HSP is excellent. Most children have complete resolution of the illness without any significant sequelae.Patients with HSP renal disease (elevated blood urea nitrogen, persistent high-grade proteinuria) are at highest risk for long-term complications, such as hypertension or renal insufficiency, particularly if the initial course was marked by significant nephritis.
There is a long-term risk of progression to end-stage renal disease in less than 1% of children with HSP. The rare patients who develop end-stage renal disease may require renal transplantation. HSP may recur in the transplanted kidney.